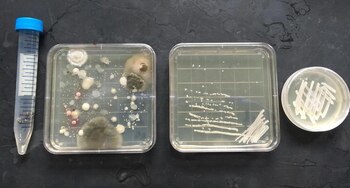
Investigadores de North Carolina State

Para quienes elaboran cerveza amarga, los insectos son oro puro.
Dailey Crafton salió caminando por la puerta trasera de su departamento en Brooklyn con dirección al jardín, un trozo de tierra cercado por una valla de metal, en busca de un brote de zucchini. Entre las fresas y la tierra, encontró la flor naranja que estaba buscando y la arrancó; se trataba del ingrediente final para su último lote de cervezas.
Pero mientras regresaba al departamento, notó una fila de hormigas marchando sobre los pétalos. Crafton, diseñador gráfico y un fornido cervecero, añadió el brote de zucchini en su cerveza sin fermentar. Esperaba que los microorganismos salvajes que vivían en los pétalos produjeran sabores únicos y ácidos.
Entonces tuvo una idea.
"Qué demonios", pensó Crafton. "Pondré las hormigas también".
Había escuchado que las abejas transportan microorganismos capaces no solo de fermentar la cerveza, sino activar sabores jugosos, claros y ácidos.
Entonces, pensó, ¿por qué las hormigas no? Y las agregó vivas.
Para quienes elaboran cerveza amarga, los insectos son oro puro; sin embargo, el término "insecto" en la destilación generalmente no se refiere a los bichos como tal. Más bien, la mayoría de cerveceros utilizan insectos de especies más pequeñas; microorganismos como levadura o bacterias presentes en el aire, así como frutas y vegetales que se fermentan y acidifican cerveza o vino, pan o queso.
Si bien hay gran cantidad de variedades, las cerveceras usan solo una o dos especies de levadura —ale o lager—, la cual compran por volumen, probadas e identificadas en laboratorios. Algunas cerveceras compran bacterias benéficas con la intención de usarlas para la elaboración de cerveza amarga, muy pocas siguen cultivando microorganismos silvestres exponiendo la cerveza sin fermentar al aire libre.

Pero últimamente, los elaboradores han mostrado interés en diversificarse y cultivar insectos dentro de insectos. La idea puede sonar al truco concebido por un estratega en mercadotecnia que bebió demasiado para vender productos locales, pero los científicos han comenzado a experimentar con una fuente de fermentación completamente nueva.
Crafton, quien enseña a realizar infusiones en The Brooklyn Kitchen, aprendió que los insectos portan microbios benéficos en sus cuerpos y estómagos gracias a Jeff Mello, quien clasifica la levadura y las bacterias de todos los códigos postales en Estados Unidos.
Los aficionados le mandan a Mello, fundador de Bootleg Biology, muestras de sus vecindarios, mismas que él guarda y registra. Un cervecero aficionado le mando una muestra de levadura que recolectó después de sumergir una abeja en mosto, o sea cerveza sin fermentar.
"Creo que las abejas procesan el néctar de las flores con sus bocas, es por eso que se puede encontrar levadura natural en la miel sin pasteurizar", explicó. "Tenemos la levadura de abeja guardada, con ella se elabora cerveza excelente".
Los científicos han sabido por años que los insectos son portadores de bichos benéficos para la fermentación. Pero no fue hasta hace pocos años que algunos comenzaron a preguntarse si funcionarían para la cerveza.

En 2014, los investigadores de la Universidad Estatal de Carolina del Norte intentaron identificar y aislar las variedades de levadura que vivían dentro de las avispas. Para probar las cepas, se pulverizó a las avispas y se añadieron los restos a una solución rica en nutrientes para que los microbios crecieran, según la investigadora Dr. Anne Madden.
Después de las pruebas genéticas para comprobar su seguridad, retiraron la levadura y la añadieron al mosto. Pero resultaba más fácil decir que hacer el salto hacia la infusión de cervezas, según Madden. A pesar de que la levadura contribuye a casi la mitad del sabor de las cervezas, Madden dice que no todas las levaduras sirven para hacer cerveza. La mayoría no funciona. Ya sea que el alcohol que producen las mata en 1 o 2 por ciento de alcohol, o producen sabores demasiado naturales que evocan establos y que la mayoría de los bebedores no quiere.
Así que cuando la cerveza resultó no solo pasable, sino buena, Madden estaba sorprendida. En algunos estilos de cerveza, la levadura produce compuestos de sabor llamados ésteres que saben a sidra de manzana y miel.
"Era sorprendentemente ácida sin sabores extraños que por lo general se esperan en las cervezas con levaduras silvestres", dijo Madden. "Cuando lanzamos la primera Wasp Beer en el World Beer Festival de Raleigh, Carolina del Norte, el público la amó y se nos terminaron antes de que el festival acabara".
Pero se dice que la levadura de avispa acidifica la cerveza, haciendo que ésta sepa amarga. La cerveza sí era ácida, pero evocaba sabores frutales. Típicamente, la cerveza amarga está elaborada con un cóctel de bacterias que puede tardar meses e incluso años en formarse. Pero la levadura de avispas sirve para hacer cerveza amarga en unas cuantas semanas, reduciendo el riesgo de agregar bacterias u otras levaduras "contaminantes" al proceso.
Madden dijo que encontraron levadura en las hormigas, pero hasta ahora solo han comercializado las cervezas con variedades de abejas seleccionadas. Ella y un profesor de procesos biológicos de la universidad patentaron la levadura y crearon una compañía para venderla a los cerveceros.
Pero si estás pensando en salir a infusionar con tus propios insectos, Madden dice que lo pienses dos veces. Su laboratorio utiliza pruebas genéticas, biológicas y químicas para asegurar que las levaduras no transmitan patógenos peligrosos a las personas.
"Los insectos son como selvas a nivel microscópico, por tanto pueden transportar cientos de especies de microorganismos dentro de ellos", dijo Madden.
Las cervezas de Crafton aún no han matado a nadie, pero también sabe exactamente cuál es su contenido. El otoño pasado sirvió su cerveza de hormigas, llamada Funky Fresh, en la Brooklyn Kitchen para un público local que buscaba algo diferente. Era naranja, brumosa y frutal, excepto por la cruda al día siguiente, la única sorpresa es lo buena que resultó: sabor limpio y ligeramente picante.

Crafton (35) se considera miembro del movimiento exclusivo de la cerveza natural, donde los elaboradores cultivan sus ingredientes en la naturaleza. Pero mientras que la mayoría son como la empresa Scratch en el estado rural de Illinois, localizada en una granja que cultiva casi todos sus ingredientes cerca del Parque Nacional Shawnee, Crafton vive en Brooklyn.
Eso no lo ha detenido de cultivar levadura silvestre al aire libre, o introducir maderos que encuentra en el parque de Brooklyn en la cerveza sin fermentar. No es la falta de dinero, recursos o conocimiento. Crafton ama hacerlo. "Muchos sitios dicen ofrecer cerveza silvestre. Pero yo voy más lejos: hago cerveza sin control".
Sus planes son destilar cerveza de ahora en adelante con troncos y, luego de comprar barriles de una bodega cercana, planea abrir su propia cervecería en Yonkers.
"No busco ser romántico, sino ser impredecible", dijo mientras bebía una cerveza de madera en una cata que ofreció en su casa. Entre las varias cervezas que descansan sobre el refrigerador, el tronco reposa para que la levadura viviente en la superficie pueda incubarse; ahora se ve blanca, como si estuviera congelada, mientras está generando microbios.
"Le digo a mis colegas que hago cerveza con madera y me preguntan, '¿De qué carajos estás hablando?' Si participara en [el programa de TV] Naked and Afraid, me abandonaran en medio de la nada y si pudiera escoger un solo objeto, escogería un palo".
Publicado originalmente por VICE.com
Últimas Noticias
Temblor en México hoy: noticias de la actividad sísmica este sábado 31 de enero de 2026
Sigue en vivo todas las actualizaciones sobre movimientos telúricos emitidas por el SSN

Las reservas netas del Banco Central son negativas en USD 14.100 millones, según el cálculo que utiliza el FMI
El dato fue incluido en un informe del BCRA y será uno de los que supervisará el Fondo Monetario en el próximo monitoreo de las metas comprometidas por el equipo de Luis Caputo

Arranca Feria del Atole y Tamal Neza 2026: todo lo que debes saber sobre este evento
Desde lo más clásico a las variaciones gourmet, los visitantes podrán acercarse a 60 expositores para disfrutar del tradicional Día de la Candelaria

Allanaron un municipio entrerriano por presuntas irregularidades en el manejo de fondos de comedores y merenderos
El procedimiento se realizó tras una denuncia en contra del gobierno municipal de La Paz. La Fiscalía secuestró abundante documentación. En los próximos días podría haber citaciones a los funcionarios involucrados


